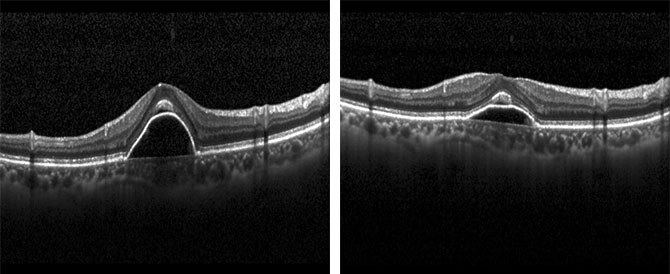
图1:治疗当天黄斑区水肿明显 图2:“布西珠单抗”治疗后10天复诊,黄斑水肿明显好转

近期,在nba直播吧-nba吧-nba看球吧 的支持下,广东省人民医院将牵头发起《评估布西珠单抗治疗难治性糖尿病性黄斑水肿的有效性与安全性的单臂临床研究》(BEST研究),是国内首个关于布西珠单抗的真实世界研究,旨在评估布西珠单抗治疗中国糖尿病性黄斑水肿患者的疗效和安全性。
“港澳药械通”新型药惠及眼底病患
“港澳药械通”是经国务院授权,允许临床急需、已在港澳上市的药品以及临床急需、港澳公立医院已采购使用、具有临床应用先进性的医疗器械,经广东省人民政府批准后,可在粤港澳大湾区指定医疗机构使用的一项政策。
截至2024年3月,“港澳药械通”政策累计批准指定医疗机构19家,发布《粤港澳大湾区内地临床急需进口港澳药品医疗器械目录》6批,审批临床急需进口港澳药品医疗器械59个,共惠及5000余人次。
该项政策不仅促进粤港澳大湾区医疗的同质化发展,而且为内地患者提供了更加便利的药品医疗器械产品及服务,很好地帮助内地患者突破地域差和时间差,享受到更先进的医疗服务,对于推动“健康大湾区”建设具有非常重要的意义。
广东省人民医院作为粤港澳大湾区“港澳药械通”指定医疗机构之一,经由该项政策引入多种进口药物和医疗器械,并于近日引进创新药物——布西珠单抗,为眼底病患者提供国际化的医疗服务。
布西珠单抗于2019年在美国上市应用,至今已在全球82个国家及地区获批上市。该药物是用于治疗湿性(新生血管性)黄斑变性(wAMD/nAMD)和糖尿病性黄斑水肿(DME)的新一代创新型药物,与国内现有的抗VEGF(血管内皮生长因子)药物相比,组织穿透性更强,能更快改善黄斑水肿及提升视力,更明显延长打针间隔,约3~4个月注射一次,改善患者依从性,大幅降低患者的治疗负担并提高患者的生活质量。
广东省人民医院完成“首针”布西珠单抗注射
67岁的张先生(化名),5年前左眼视力下降明显,并伴有视物黑影,经医院检查确诊为湿性老年性黄斑变性,由于缺乏对该种疾病的认识,导致张先生未能重视早期及时地进行左眼的治疗,尽管经过第一代抗VEGF(血管内皮生长因子)药物玻璃体腔注射治疗,病情得到了有效控制,但左眼的视力并没有恢复如初。
近期,张先生右眼同样确诊为湿性老年性黄斑变性,一经确诊张先生立马咨询广东省人民医院眼科专家,希望能够得到更好的治疗方法,对此医院眼科专家团队进行了详尽的讨论,在遵从患者意愿的原则下,得出了最优的治疗方案——使用“港澳药械通”新一代小分子抗VEGF(血管内皮生长因子)药物布西珠单抗进行玻璃体腔注射治疗。
经过多方的共同协调,张先生在布西珠单抗进入医院的第一时间获得了首针治疗。2024年5月20日,眼科余洪华主任为张先生的右眼进行了布西珠单抗注射,术程顺利。对于所有医务人员的辛苦努力,张先生表达了真诚的感谢。

图1:治疗当天黄斑区水肿明显 图2:“布西珠单抗”治疗后10天复诊,黄斑水肿明显好转
真实世界研究(Real World Study,RWS)
是一种以真实世界数据为基础,评价药品安全性和有效性的方法。
相较于随机对照试验,真实世界研究涵盖了更广泛的患者群体,并能收集分析卫生信息系统、医保系统、疾病登记系统等更多源的信息数据,获得药品使用情况及潜在获益-风险临床证据。真实世界研究的评估结果可作为实际临床应用评估的有力补充。
2020年至今,《真实世界证据支持药物研发与审评的指导原则(试行)》等技术指导原则发布,为真实世界研究工作开展搭建了基本框架,对促进我国药物研发、评价与监管起到积极作用。








